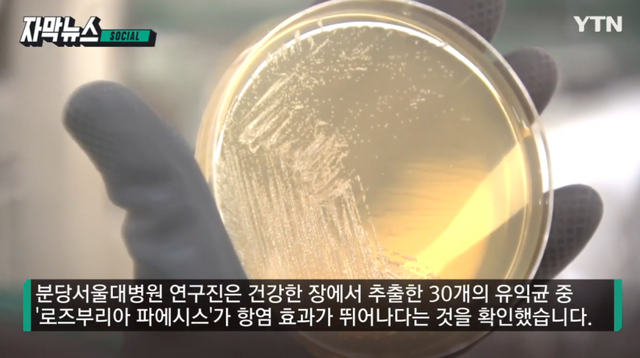

현대인 10명 중 한명 꼴로 발생할 정도의 병인 ‘과민성 대장 증후군.’
이 병은 후천적 스트레스랑 연관이 있는게 분명한데,
아직까지 어떤 원리로 발생하는지 밝혀지지 않았었음.





그런데 미국이랑 중국의 공동연구로 원인이 밝혀짐.
바로 스트레스가 장속에 특정 균을 자극하면 성분을 뿜어내는데
이 성분이 장 줄기세포에 악영향을 줘서 장 보호 세포가 제대로 안 만들어 지는게 바로 ‘과민성 대장 증후군’이었음.

이 과민성 대장 증후군이 신기한게, 성별에따라 민감도도 달랐다고 함.
남자가 좀 더 민감하게 나타났었고 그래서 장내 유익균 투여했을 때 효과도 더 좋게 나온다고 함.
Copyright ⓒ 유머갤럭시 무단 전재 및 재배포 금지
본 콘텐츠는 뉴스픽 파트너스에서 공유된 콘텐츠입니다.



